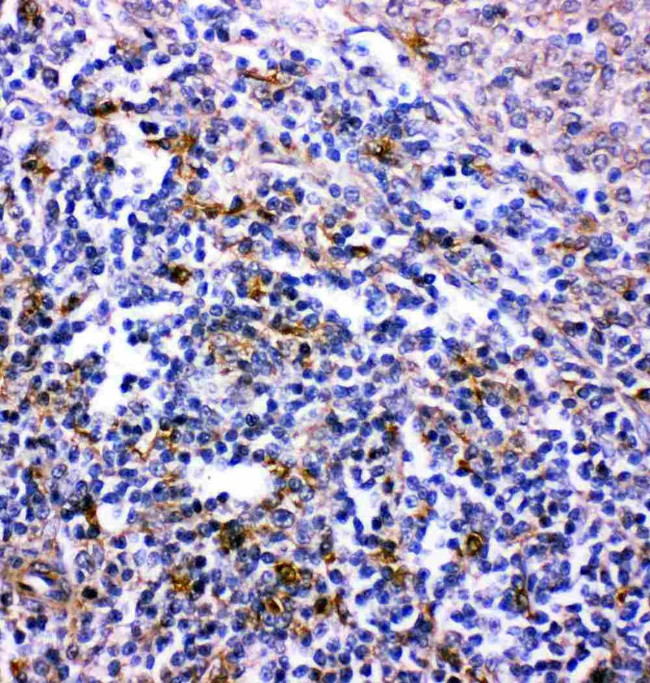
CXCR6 Antibody in Immunohistochemistry (Paraffin) (IHC (P))

Search
Invitrogen
CXCR6 Polyclonal Antibody
{{$productOrderCtrl.translations['antibody.pdp.commerceCard.promotion.promotions']}}
{{$productOrderCtrl.translations['antibody.pdp.commerceCard.promotion.viewpromo']}}
{{$productOrderCtrl.translations['antibody.pdp.commerceCard.promotion.promocode']}}: {{promo.promoCode}} {{promo.promoTitle}} {{promo.promoDescription}}. {{$productOrderCtrl.translations['antibody.pdp.commerceCard.promotion.learnmore']}}
产品信息
PA5-79117
宿主/亚型
分类
类型
抗原
偶联物
形式
浓度
规格
保存条件
运输条件
RRID
产品详细信息
Reconstitute with 0.2 mL of distilled water to yield a concentration of 500 µg/mL.
Positive Control - WB: Rat Brain Tissue, Rat Testis Tissue, Rat Spleen Tissue, Mouse Brain Tissue, Mouse Testis Tissue. IHC: Rat Spleen Tissue.
靶标信息
CD186, also known as CXCR6, is a G protein-coupled chemokine receptor reported to be one of the cellular receptors of HIV and SIV. CD186 is expressed by NKT cells, various subtypes of T cells with activated and memory phenotypes, and some plasma cells. It has been reported that mouse liver NK cells, but not naïve or splenic NK cells, express CD186. The ligand of CD186, CXCL16, is expressed by macrophages, dendritic cells and liver endothelial cells. Being highly expressed on NKT cells, CD186 is often used as a proxy marker of this cell subset.
⚠WARNING: This product can expose you to chemicals including mercury, which is known to the State of California to cause birth defects or other reproductive harm. For more information go to www.P65Warnings.ca.gov.
仅用于科研。不用于诊断过程。未经明确授权不得转售。